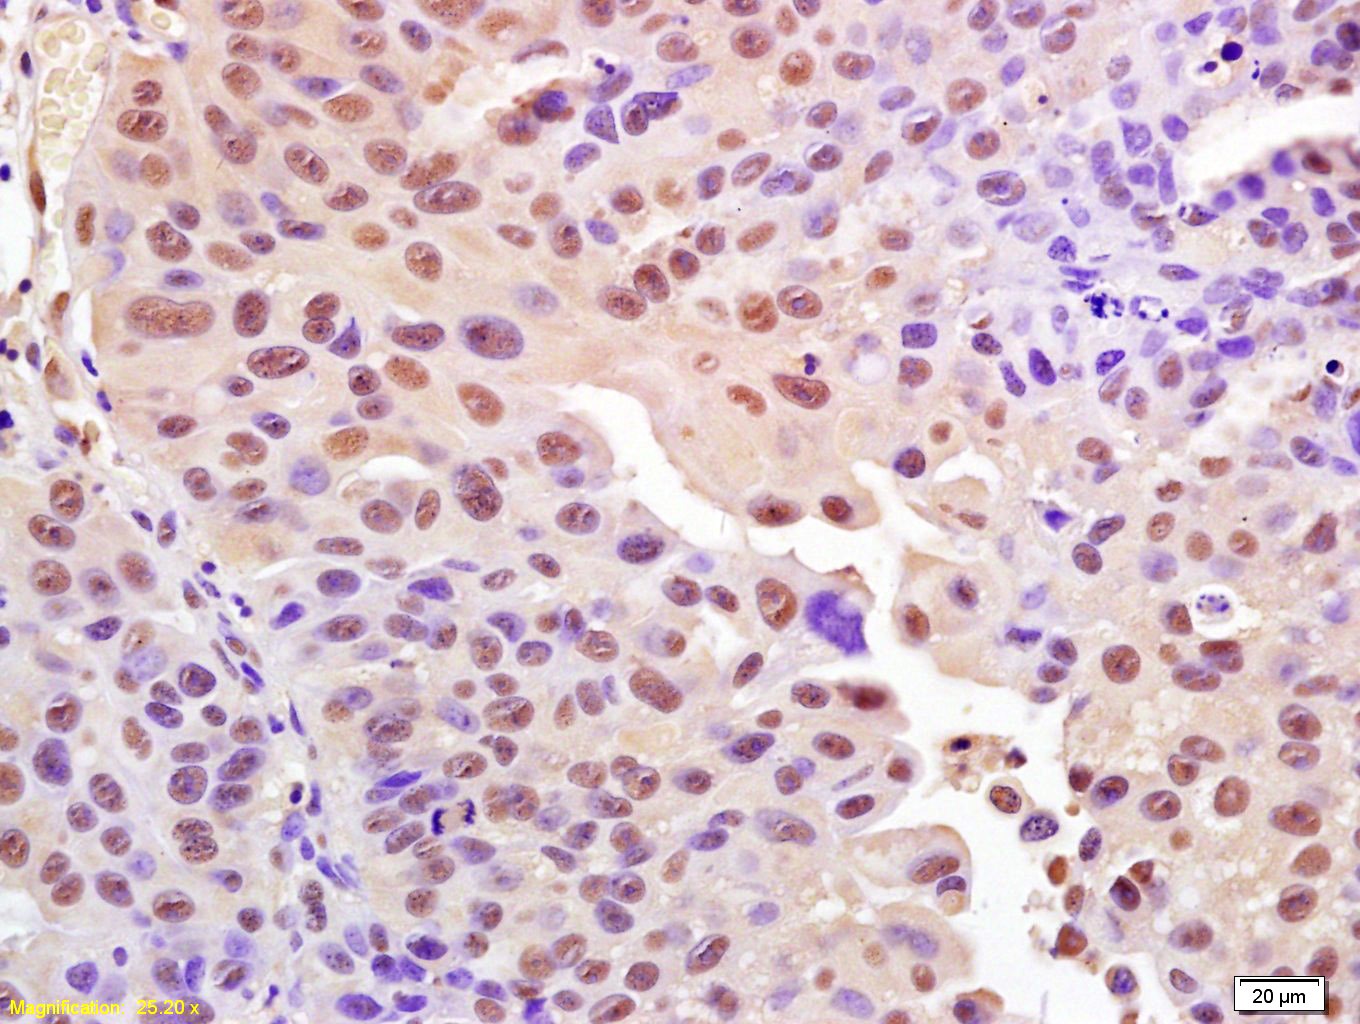

购物车
 您的购物车当前为空
您的购物车当前为空
Anti-Phospho-H2AFX (Ser139) Polyclonal Antibody 是一种 Rabbit 抗体,靶向 Phospho-H2AFX (Ser139)。Anti-Phospho-H2AFX (Ser139) Polyclonal Antibody 可用于 FCM,IF,IHC-Fr,IHC-P,WB。
别名 Phospho-Histone H2AX (S139), p-Histone H2AX (Ser139), p-Histone H2AX (S139), Histone H2AX (p-Ser139), Histone H2AX (p-S139)
Anti-Phospho-H2AFX (Ser139) Polyclonal Antibody 是一种 Rabbit 抗体,靶向 Phospho-H2AFX (Ser139)。Anti-Phospho-H2AFX (Ser139) Polyclonal Antibody 可用于 FCM,IF,IHC-Fr,IHC-P,WB。
| 规格 | 价格 | 库存 | 数量 |
|---|---|---|---|
| 50 μL | ¥ 1,160 | 5日内发货 | |
| 100 μL | ¥ 1,970 | 5日内发货 | |
| 200 μL | ¥ 2,780 | 5日内发货 |
TargetMol的所有产品仅用作科学研究或药证申报,不能被用于人体,我们不向个人提供产品和服务。请您遵守承诺用途,不得违反法律法规规定用于任何其他用途。
| 产品描述 | Anti-Phospho-H2AFX (Ser139) Polyclonal Antibody is a Rabbit antibody targeting Phospho-H2AFX (Ser139). Anti-Phospho-H2AFX (Ser139) Polyclonal Antibody can be used in FCM,IF,IHC-Fr,IHC-P,WB. |
| 别名 | Phospho-Histone H2AX (S139), p-Histone H2AX (Ser139), p-Histone H2AX (S139), Histone H2AX (p-Ser139), Histone H2AX (p-S139) |
| Ig Type | IgG |
| 反应种属 | Human,Mouse,Rat (predicted:Dog,Pig,Cow,Horse,Rabbit) |
| 验证活性 | 1. Tissue/cell: human bladder carcinoma; 4% Paraformaldehyde-fixed and paraffin-embedded; Antigen retrieval: citrate buffer (0.01M, pH6.0), Boiling bathing for 15 min; Block endogenous peroxidase by 3% Hydrogen peroxide for 30 min; Blocking buffer (normal goat serum) at 37°C for 20 min; Incubation: Anti-Phospho-Histone H2A.x (Ser139) Polyclonal Antibody, Unconjugated (TMAB-01418) 1:200, overnight at 4°C, followed by conjugation to the secondary antibody and DAb staining. 2. Blank control: Molt4. Primary Antibody (green line): Rabbit Anti-Phospho-Histone H2A.X (Ser139) antibody Dilution: 1 μg/10^6 cells; Isotype Control Antibody (orange line): Rabbit IgG. Secondary Antibody: Goat anti-rabbit IgG-APC Dilution: 1 μg/test. Protocol The cells were fixed with 4% PFA (10 min at room temperature) and then permeabilized with 90% ice-cold methanol for 20 min at-20°C. The cells were then incubated in 5% BSA to block non-specific protein-protein interactions for 30 min at room temperature. Cells stained with Primary Antibody for 30 min at room temperature. The secondary antibody used for 40 min at room temperature. 3. Blank control: Hela. Primary Antibody (green line): Rabbit Anti-Phospho-Histone H2A.X (Ser139) antibody (TMAB-01418) Dilution: 2 μg/10^6 cells; Isotype Control Antibody (orange line): Rabbit IgG. Secondary Antibody: Goat anti-rabbit IgG-FITC Dilution: 1 μg/test. Protocol The cells were fixed with 4% PFA (10 min at room temperature) and then permeabilized with 90% ice-cold methanol for 20 min at-20°C. The cells were then incubated in 5% BSA to block non-specific protein-protein interactions for 30 min at room temperature. Cells stained with Primary Antibody for 30 min at room temperature. The secondary antibody used for 40 min at room temperature. 4. Sample: Lane 1: Mouse BV2 cell lysates Lane 2: Rat Testis tissue lysates Lane 3: Human 293T cell lysates Lane 4: Human Jurkat cell lysates Primary: Anti-Phospho-H2AX (Ser139) (TMAB-01418) at 1/5000 dilution Secondary: IRDye800CW Goat Anti-Rabbit IgG at 1/20000 dilution Predicted band size: 16 kDa Observed band size: 15 kDa |
| 应用 | FCMIFIHC-FrIHC-PWB |
| 推荐剂量 | WB: 1:500-2000; IHC-P: 1:100-500; IHC-Fr: 1:100-500; IF: 1:100-500; FCM: 2ug/Test |
| 抗体种类 | Polyclonal |
| 宿主来源 | Rabbit |
| 亚细胞定位 | Nucleus. Chromosome. |
| 构建方式 | Polyclonal Antibody |
| 纯化方式 | Protein A purified |
| 性状 | Liquid |
| 缓冲液 | 0.01M TBS (pH7.4) with 1% BSA, 0.02% Proclin300 and 50% Glycerol. |
| 浓度 | 1 mg/mL |
| 研究背景 | Histones are basic nuclear proteins that are responsible for the nucleosome structure of the chromosomal fiber in eukaryotes. Two molecules of each of the four core histones (H2A, H2B, H3, and H4) form an octamer, around which approximately 146 bp of DNA is wrapped in repeating units, called nucleosomes. The linker histone, H1, interacts with linker DNA between nucleosomes and functions in the compaction of chromatin into higher order structures. This gene encodes a member of the histone H2A family, and generates two transcripts through the use of the conserved stem-loop termination motif, and the polyA addition motif. [provided by RefSeq, Jul 2008]. |
| 免疫原 | KLH conjugated Synthesised phosphopeptide: human Histone H2AX around the phosphorylation site of Tyr139 |
| 抗原种属 | Human |
| 基因名称 | H2AX |
| 基因ID | |
| 蛋白名称 | Histone H2AX |
| Uniprot ID | |
| 研究领域 | ChIP antibodies,DNA Damage Recognition,Unmodified,Variants |
| 功能 | Variant histone H2A which replaces conventional H2A in a subset of nucleosomes. Nucleosomes wrap and compact DNA into chromatin, limiting DNA accessibility to the cellular machineries which require DNA as a template. Histones thereby play a central role in transcription regulation, DNA repair, DNA replication and chromosomal stability. DNA accessibility is regulated via a complex set of post-translational modifications of histones, also called histone code, and nucleosome remodeling. Required for checkpoint-mediated arrest of cell cycle progression in response to low doses of ionizing radiation and for efficient repair of DNA double strand breaks (DSBs) specifically when modified by C-terminal phosphorylation. |
| 分子量 | Theoretical: 16 kDa. Actual: 15 kDa. |
| 储存方式 | Store at -20°C or -80°C for 12 months. Avoid repeated freeze-thaw cycles. |
| 运输方式 | Shipping with blue ice. |